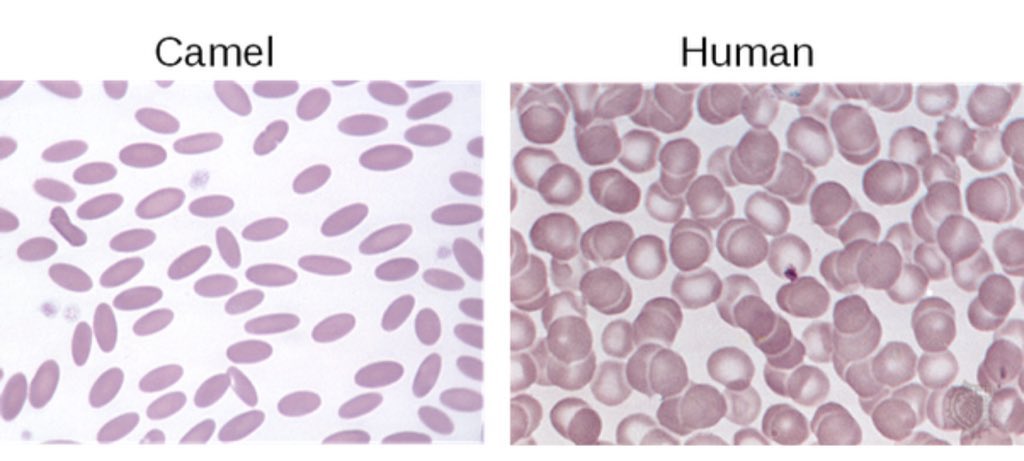

ليس بالضرورة أن البقع الدمويه تسقط دائماً من إنسان، فعندما يعثر عليھا في مسرح الجريمة فإنه يتوجب على المحقق فحصھا لمعرفة هل البقع دمويه ام لا ؟
وهل الدم آدمي ام حيواني !!
وكيف نتوصل لنوع الحيوان من عينة الدم ؟!
وهل الدم آدمي ام حيواني !!
وكيف نتوصل لنوع الحيوان من عينة الدم ؟!
يتكون الدم من كرات حمراء والتي تجعل الدم احمراً لاحتوائھا هيموجلوبين الدم وتوجد بمعدل خمسة ملايين وحدة في ملم٢ وايضاً خلايا الدم البيضاء ' التي تحتوي على نواة الحمض النوي DNA ' وصفائح دموية وبلازما.
اختبار كاستل-ماير 'Kastle-Meyer test'
يعد هذا الاختبار أحد الاختبارات السھله في المختبرات الجنائية للكشف عن وجود بقايا دماء في العينة المفحوصة.
ويعرف كاشف كاستل-ماير بأنه مركب الفينول فثالين Phenolphthalin وهو عديم اللون.
يعد هذا الاختبار أحد الاختبارات السھله في المختبرات الجنائية للكشف عن وجود بقايا دماء في العينة المفحوصة.
ويعرف كاشف كاستل-ماير بأنه مركب الفينول فثالين Phenolphthalin وهو عديم اللون.
يسأل البعض !! مالفائدة من معرفة اذا كان مصدر الدم حيواني ؟
قد يكون ذلك الحيوان يعود للجاني او للضحية وربما استخدم هذا الحيوان في هذه القضية 'كالكلاب' فمعرفة نوع الحيوان يفسر الكثير لسير التحقيقات الجنائية ويضيق دائرة البحث والتحري.
قد يكون ذلك الحيوان يعود للجاني او للضحية وربما استخدم هذا الحيوان في هذه القضية 'كالكلاب' فمعرفة نوع الحيوان يفسر الكثير لسير التحقيقات الجنائية ويضيق دائرة البحث والتحري.
جاري تحميل الاقتراحات...